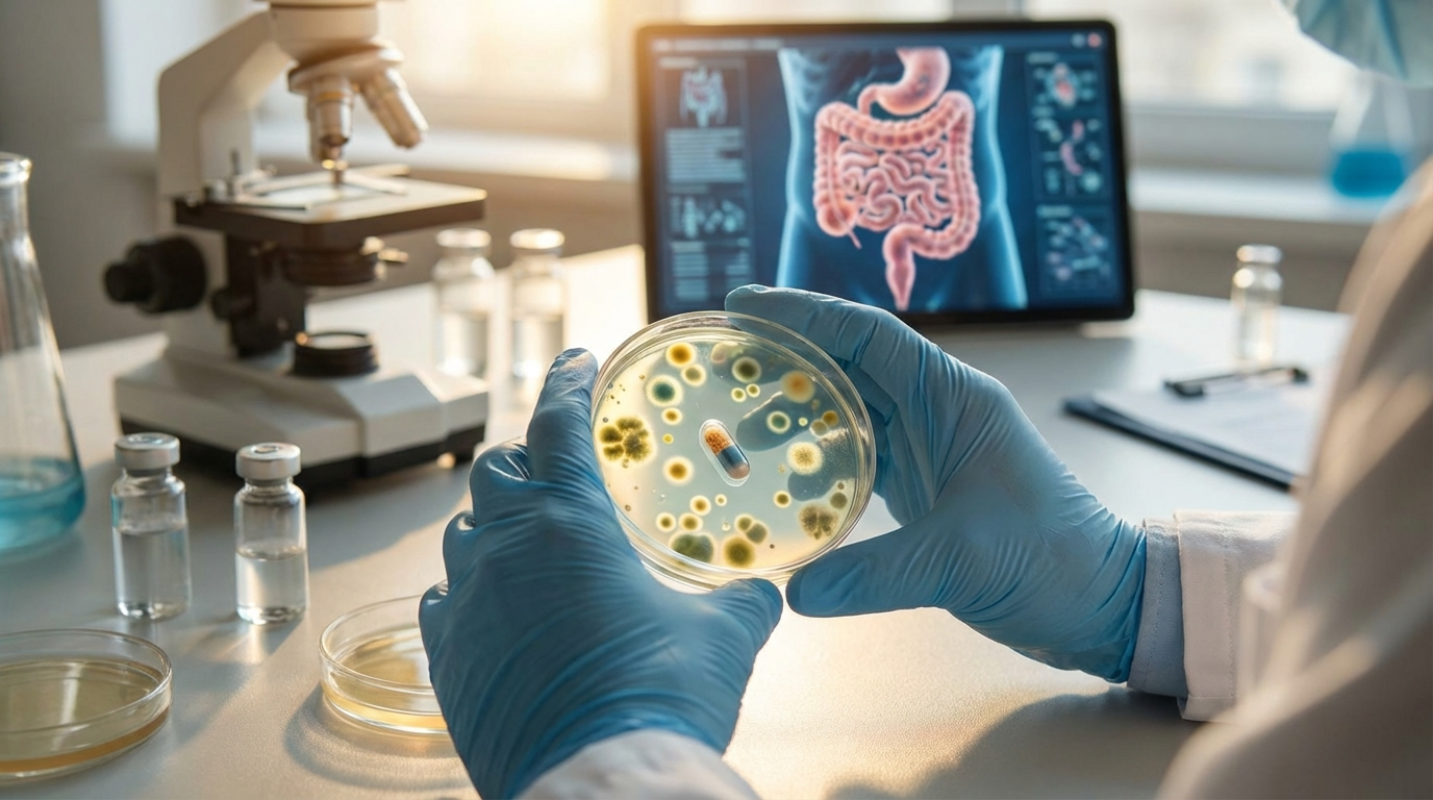

The human gut microbiome—that bustling, complex city of trillions of bacteria, fungi, and viruses living inside you—is rapidly transforming the space of gastrointestinal (GI) medicine. For decades, GI treatments often relied on broad strokes: anti-inflammatories, immunosuppressants, or general antibiotics. That’s changing. We’re moving into an era of hyper-precision, where treating chronic conditions means targeting the specific microbial imbalances, or dysbiosis, that drive disease.
Why is this shift happening now? Because we finally recognize the microbiome isn't just a passive resident helping you digest dinner. It’s an active organ, important for immune education, synthesizing needed vitamins, and maintaining the integrity of your intestinal barrier. When this system breaks down, it contributes directly to conditions like Inflammatory Bowel Disease (IBD), Irritable Bowel Syndrome (IBS), and even colorectal cancer. The market reflects this urgency; the global human microbiome sector, valued at nearly $1 billion in 2024, is projected to exceed $5.1 billion by 2030, signaling massive investment in these targeted solutions.²
This is the gut revolution, and it requires specialized tools. If traditional medicine used a sledgehammer, microbiome-targeted therapies use a customized scalpel. You’re about to see how these innovative approaches—from defined bacterial cocktails to highly selective viruses—are moving out of the lab and into the clinic.
Pillar 1: Restoring Balance – FMT and Next-Generation Probiotics
The concept of microbial restoration began with Fecal Microbiota Transplantation (FMT). FMT is exactly what it sounds like: introducing stool from a healthy donor into a patient’s GI tract to repopulate the microbial community.
FMT has proven to be a stunning success story, particularly in treating recurrent Clostridioides difficile infection (rCDI). For patients suffering from repeated, life-threatening CDI episodes, FMT often works where antibiotics fail, having success rates as high as nine out of ten patients. This efficacy validated the entire field.
The Shift from "Black Box" to Defined Consortia
Although it has success, traditional FMT has limitations. It’s a "black box" product; you don’t know every single organism you’re introducing, raising safety concerns, especially the risk of transmitting undetected pathogens.
This is why regulators and developers are pivoting hard toward Defined Microbial Consortia, often categorized as Live Biotherapeutic Products (LBPs). These are standardized, manufactured pills or liquids containing specific, beneficial bacterial strains chosen for their known function.
The FDA’s approval of two first-in-class LBPs, Rebyota® and Vowst™, for preventing rCDI, solidified this transition.¹ These products eliminate the variability and safety risks of donor stool while providing the same therapeutic benefit. The goal now is to rationally design a product that can perfectly recapitulate the functionality of FMT in a safer, scalable drug-like format. We're moving beyond general probiotics (like store-bought Lactobacillus and Bifidobacterium strains) toward strain-specific candidates designed to achieve a precise mechanism, such as metabolizing bile acids or reducing inflammation.
Pillar 2: Precision Targeting – Phages, Postbiotics, and Small Molecules
If LBPs are about restocking the gut with good players, precision therapies are about actively shaping the existing environment. These tools offer highly targeted manipulation without the broad collateral damage caused by traditional antibiotics.
Bacteriophages: The Selective Assassins
Imagine a therapy that kills only the bad bacteria without harming the millions of beneficial commensals. That’s the promise of Bacteriophages (Phages). Phages are naturally occurring viruses that infect and destroy specific bacterial species.
In gastroenterology, phages are being investigated to selectively eliminate pathogens or microbial strains linked to disease—like, targeting strains of Klebsiella pneumoniae that are often enriched during IBD flare-ups. This approach offers a standardized, scalable alternative to broad-spectrum treatments. Clinical trial activity in this area is skyrocketing, with 32 phage therapy trials registered worldwide between 2020 and 2024, focusing on modulating bacteria-related pathologies, including GI disorders.⁵
Postbiotics: Using Microbial Byproducts
Sometimes, you don't need the bacteria itself; you just need what the bacteria produces. Postbiotics are the beneficial metabolites created by gut microbes. The most famous examples are Short-Chain Fatty Acids (SCFAs), particularly butyrate.
Butyrate is the primary fuel source for your colonocytes (the cells lining the colon). It’s needed for maintaining the gut barrier function and reducing inflammation. Postbiotic therapies involve delivering these compounds directly as therapeutic agents, bypassing the need for the patient’s own microbiome to produce enough of them. Think of it as giving the engine fuel directly, rather than relying on the driver to fill the tank.
Small Molecule Therapies
Beyond biological products, researchers are developing small molecule drugs designed to modulate the gut environment. These drugs don't necessarily contain live bacteria, but they might target specific microbial pathways or increase the diversity of beneficial species. This allows doctors to fine-tune the gut ecosystem with prescription-level control.
Clinical Applications: IBD and the Gut-Brain Axis
Although CDI success is established, the major clinical hurdle now is tackling chronic, complex diseases like IBD (Crohn’s disease and Ulcerative Colitis) and IBS.
For IBD, the goal is not merely to restore diversity but to introduce specific anti-inflammatory functions. Clinical trials are showing real promise. One large-scale European trial for mild-to-moderate Ulcerative Colitis, using a defined microbial consortium (MH002), has shown significant anti-inflammatory effects. Early data revealed an 18% clinical remission rate and a 42% median reduction in fecal calprotectin, a key inflammatory biomarker.³
Plus, personalized medicine is entering the space. Therapies based on personalized microbiome modulation (PMM), which tailor treatment to an individual’s unique microbial profile, have shown marked clinical improvements in patients with moderate-to-severe IBD, including a 58% reduction in stool frequency and decreases in systemic inflammation.⁴ This level of customization is the future.
Key Therapeutic Considerations in Microbiome Medicine
- Diagnosis is Key — Before therapy, complete metagenomic sequencing is necessary to understand the patient’s specific dysbiosis profile.
- Personalization — Effective treatments for IBD and IBS often require tailored approaches based on individual microbial deficits, not one-size-fits-all probiotics.
- Combination Therapy — The most successful outcomes often combine targeted microbial restoration (LBPs) with dietary changes and postbiotic support (SCFAs).
The Integration Challenge: AI, Regulation, and the Future
We’ve reached a important inflection point. The science is incredible, but the transition to standard clinical care faces practical challenges.
First, there’s the regulatory pathway. Live Biotherapeutic Products (LBPs) are complex. They are not traditional chemical drugs, nor are they simply food supplements. The FDA and EMA must make sure standardization, manufacturing quality, and strong quality control for these living therapies.
Second, the complexity of the data is staggering. The rise of AI and metagenomic sequencing isn’t just a buzzword here; it’s a necessity. We need artificial intelligence to analyze the vast amounts of genetic data produced by the gut to truly personalize treatments. Currently, trials often use broad consortia, but the future involves identifying exactly which three strains you need, and which five strains your neighbor needs, based on millions of data points.
Microbiome-targeted therapies aren't just a new class of drugs; they represent a fundamental shift in how we view health and disease. By 2030, Live Biotherapeutic Products are projected to become the dominant prescription category, potentially overtaking traditional FMT. This integration means that soon, your gastroenterologist won't just ask about your symptoms; they’ll ask about your microbes, and they’ll have the precision tools to fix the imbalance, paving the way for a new standard of personalized GI care.
Sources:
1. Microbiome Disease Clinical Trial Analysis
2. Human Microbiome Market Clinical Trials Pipeline
3. Microbiome Pill for Ulcerative Colitis Clears FDA for Major Trial
4. Personalized Microbiome Modulation Showed Significant Clinical Improvements
5. Phage Therapy Clinical Trials Registered Worldwide
This article is for informational and educational purposes only. Readers are encouraged to consult qualified professionals and verify details with official sources before making decisions. This content does not constitute professional advice.
(Image source: Gemini / Landon Phillips)
(Image source: Gemini / Landon Phillips) 





